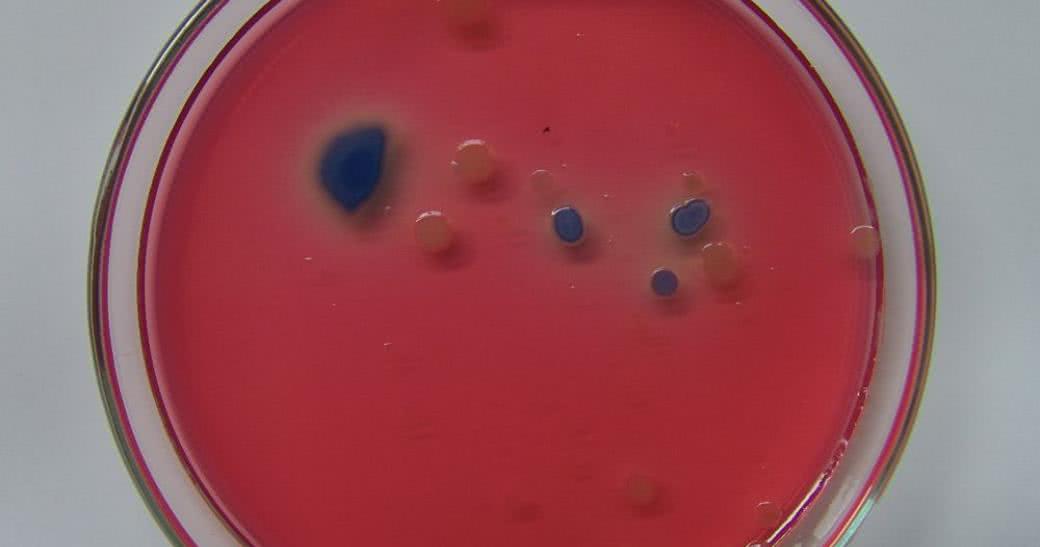

Każde dziecko, nie mówiąc o dorosłych, słyszało o globalnym ociepleniu. Al Gore, były wiceprezydent USA, zapracował na pokojową nagrodę Nobla wylansowaniem terminu "globalne ocieplenie" (global warming). Niestrudzenie podróżował po całym świecie z pokazem filmu "Niewygodna prawda" (Inconvenient Truth), który porusza sugestywną wizją Apokalipsy wywołanej topnieniem lodów wskutek zawinionego działalnością ludzką ocieplenia klimatu.
Przydałby się taki skuteczny ambasador innej globalnie ważnej sprawy, uświadamiający światu inną "niewygodną prawdę" o nieuchronnie nadciągającej katastrofie humanitarnej wskutek uodpornienia mikrobów na antybiotyki.
W poważnych raportach rządowych (na przykład w Wielkiej Brytanii) prognozuje się, że w roku 2050 oporność mikrobów na antybiotyki spowoduje więcej zgonów niż rak, a koszty walki z tym zagrożeniem będą większe niż dochód całej obecnej gospodarki świata.
Już teraz na świecie ponad 700 tys. osób umiera rocznie z powodu zakażenia bakteriami opornymi na antybiotyki. W najbardziej optymistycznych prognozach eksperci szacują, że około 2050 r. bakterie będą rocznie zabijać ponad 10 mln osób, czyli co 3 sekundy umrze jedna osoba, często z powodu banalnych dziś infekcji, podczas porodu, zabiegów chirurgicznych lub w wyniku zwykłego skaleczenia.
Zdążyliśmy już zapomnieć, jak świat wyglądał bez antybiotyków. Jeszcze sto lat temu infekcje bakteryjne dziesiątkowały ludność. Powszechna dostępność antybiotyków zmieniła sytuację radykalnie. Jednak prawa ewolucji działają i mikroby nie oddają pola bez walki, z czasem uodporniły się na poszczególne antybiotyki.
Przemysł farmaceutyczny podjął wyzwanie i ciągle próbuje zaskoczyć świat bakterii nowymi antybiotykami, na które mikroby jeszcze się nie uodporniły. Już widać, że sam przemysł farmaceutyczny nie wygra tej wojny z mikrobami. Koszty opracowania nowych antybiotyków stają się niebotyczne, a z drugiej strony ludzie niefrasobliwie nadużywają antybiotyków, co sprzyja procesowi przyśpieszania mutacji i uodparniania bakterii.
Dotyczy to nie tylko leczenia pacjentów, ale również, a może przede wszystkim, hodowli zwierząt. Wszelkie infekcje zwierząt hodowlanych, na przykład częste choroby kończyn u krów, najchętniej leczone są antybiotykami, którymi następnie faszerujemy się, pijąc mleko. Inny przykład - łosoś hodowany na fermie. Obliczono, że w czasie swojego życia taki łosoś zjada więcej antybiotyków niż wynosi jego waga. Amatorom łososia - smacznego i na zdrowie!
Co robić?
Stopniowo rośnie świadomość zagrożenia. Świat medycyny konwencjonalnej coraz życzliwiej spogląda na terapie proponowane przez medycynę alternatywną, na ziołolecznictwo i medycynę tradycyjną. Jest oczywiste, że wynalazek antybiotyków (pierwszym antybiotykiem była penicylina wyizolowana z pleśni przez Alexandra Fleminga w 1938 roku) dał medycynie niezwykle skuteczny oręż w walce z bakteriami. Jednak nadużywanie tych cudownych leków prowadzi do katastrofy.
W tej sytuacji najbardziej racjonalnym rozwiązaniem jest leczenie holistyczne, łączące powściągliwe stosowanie leków konwencjonalnych, w tym antybiotyków, i metod terapeutycznych medycyny alternatywnej.
Wydawca magazynu "Holistic Health"
(przejrzyj bieżący numer)

 Nasze magazyny
Nasze magazyny